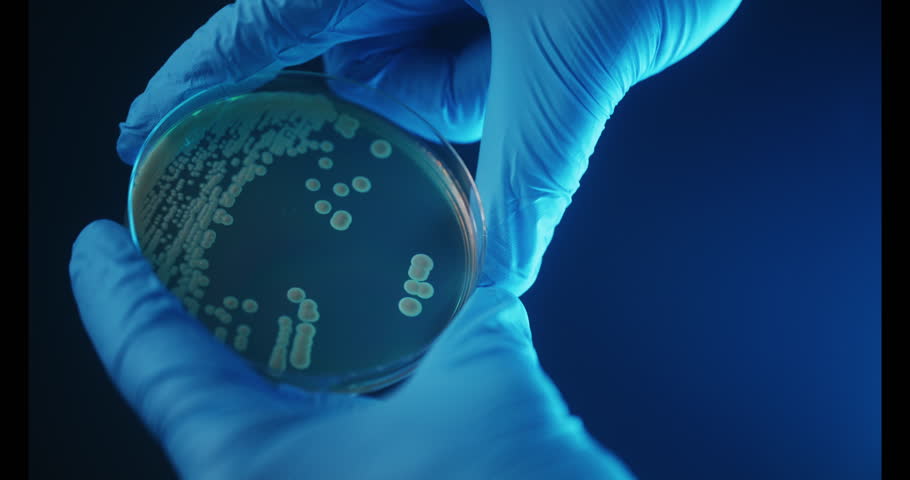

Лаборатория бактерии
Итоговое сочинение 10 11 класс
Сравните городской и сельский дома
1 реал бразилия в рублях
Подсистема семья
Бублик кондитерская томск
Как вкусно приготовить патиссоны на ужин
Ты куда что ответить
Целевая комплексная программа
Заседание нак
Амитивилль 2025
Маршрут с заездами
Пикамилон 0 2
Я уже в лесу
Лаборатория бактерии 113 фото